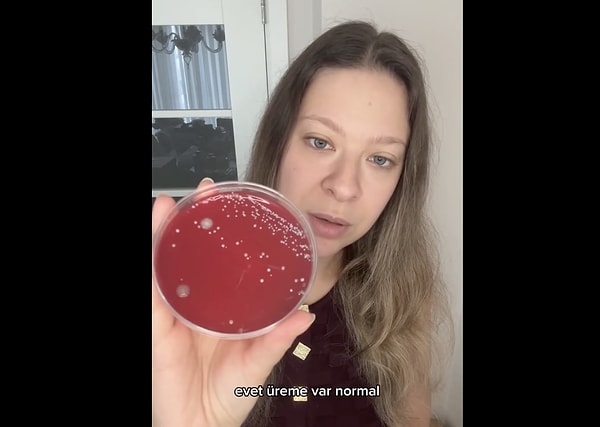
Tırnak altında biriken bakteriler, çeşitli sağlık sorunlarına yol açabiliyor.

Uzun tırnaklar, birçok kişi için bir tutku. Ancak bu tutku, hijyen sorunlarını da beraberinde getirebiliyor. Bu durum, genellikle dikkate alınmayan bir ayrıntı olsa da, uzun tırnakların bakımı ve temizliği konusunda hassasiyet gösterilmesi gerekiyor. Uzun tırnakların dışkı bakterilerinin yüzümüze ulaşmasına sebep olacağı söyleniyor. Peki bu doğru mu?
Genetik Mühendisi Dilara Sarı, uzun ve kısa tırnaklardan aldığı örnekleri besiyerine ekere sonuçları karşılaştırdı. Çıkan sonuç elbette şaşırtmadı.
Önce örnekler alındı;
Tırnak altında biriken bakteriler, çeşitli sağlık sorunlarına yol açabiliyor.
Bu nedenle, uzun tırnak kullananların, hijyen kurallarına dikkat etmesi ve tırnaklarını düzenli olarak temizlemesi gerekiyor.
Dilara Sarı'nın aldığı örneklerin sonuçları, bununla ilgili görüşleri destekler nitelikteydi. Yaşanan bir aksilik sebebiyle örneklerden birini inceleyemese de sonuç netti.
Buradan izleyebilirsiniz;
👇




Keşfet ile ziyaret ettiğin tüm kategorileri tek akışta gör!





Yorum Yazın
Ben kısa tırnaktan yanayım... Uzun tırnak hijyenik değil..
Biri de dokuya zarar vermeden en net nasıl temizlenir, özel temizleyici önerisi yapsın, bilen varsa haber etsin... Çünkü biliyoruz ki antibakteriyel likit sa... Devamını Gör
Uzun kullanmayı gençken severdim açıkçası şimdi işim gereği kullanamıyorum özel günlerde protez yaptırdığım oluyor (sağlık sektöründeyim) bunun ne yazık ki b... Devamını Gör